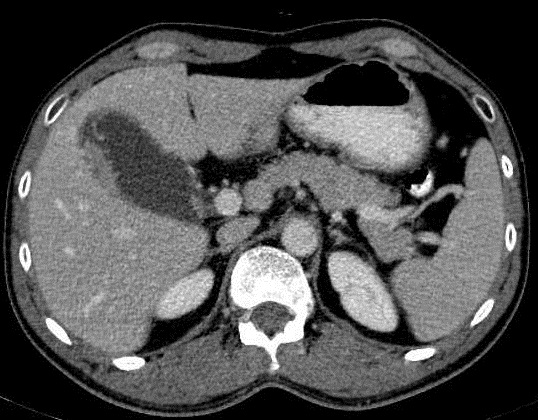

|
Pathologie radiologique de voie biliaire accessoire ( canal cystique et vesicule biliaire ) :
( a suivre )
- Tumeurs malignes vesiculaires
: 90% cancer de la vesicule biliaire est
adenocarcinoma , les autres est papiloma . Les facteurs
de risque en adjuvant de cancer de la vesicule biliaire sont
: Cholecystite chronique , calcul de la vesicule biliaire (
presense en 70-90% des cas ) , polyp vesiculaire (>1cm ) ,
vesicule en pocelaine , syndrome adenopolypoide familial (
FAP) et les colites chroniques . Image radiologique et
echographique de adenocarcinoma sont : la presence une masse
intraluminal vesiculaire ; epaissisement de paroi
vesicullaire ; calcul de grand taille vesiculaire( 60-90% )
et image de l'extension ganglionaire hilaire et extension du segment IV du foie
...
Image echographique de adenocarcinoma vesiculaire
: C'est image de masse isoechogene intraluminal a bord
irregulier , image de epaissisement de la paroi vesiculaire
et de deplacement de la vesicule biliaire avec grand calcul
vesiculaire . Image TDM et
IRM de adenocarcinoma vesiculaire est : En dehors des
images pathologique predisposante on peut en voyait encore
image de dilatation des voies biliaire intrahepatique ,
lymphadenopathie , lesion de l'extension hepatique et lesion metastasique .. .. La PET CT
est la technique d'utilise pour d'explorer de
l'extension de lesion et la metastase ..
| |
 |
|
 |
|
| |
Aspect echographique d'une
adenocarcinoma vesiculaire : Image une masse
hyperechogene heterogene a bord irregulier
intraluminal avec epaissisement de la paroi en se voyant tres nette . Image de gros calcul a
infundibulum de la vesicule biliaire ( cone
acoustique posterieure ) |
|
Adenocarcinoma vesiculaire ,
forme infiltrative : Paroi vesiculaire est tres epais,
irreguliee avec un bourgeon intraluminal vesiculaire
. Image echographique percutane en coupe
longitudinale de la vesicule biliaire |
|
| |
 |
|
 |
|
| |
Aspect de epaississement a
bord irregulie de la vesicule biliaire avec image de
mass isoechogene intraluminal vesiculaire
. Image de grand calcul avec zone d'ombre
posterieure est en vue tres nette |
|
Aspect echographique d'une adenocarcinoma
vesiculaire situe au fond de la vesicule biliaire en
mass de bourgeon ratache au paroi et sa bord tres
irregulierement . Epaississement de paroi
vesiculaire et image de calcul a infundibulum de la
vesicule biliaire sont en voyait . |
|
Image TDM et IRM
| |
|
|
 |
|
| |
Aspect
radiologique TDM d'une adenocarcinoma au fond
de la vesicule biliaire : Image de prostruction
intramural a bord tres irregulie . Adenopathie
perihilaire peut en voyait . ( Image TDM + contrast
phase veineuse , en coupe axiale ) . |
|
Image TDM + contrast intraveineuse en
coupe axiale : Aspect d'une adenomecarcinoma de la
vesicule biliaire , epaissisement de la paroi et
image de lesion infitrative au bas de la vesicule ,
rehaussement par de contrast ( fleche rouge ) .
Image de calcul arrondie hyperdense a infundibulum
est tres nette . Adenopathie hilaire hepatique et
coeliomesenterique est encore se presente |
|
| |
 |
|
 |
|
| |
Adenocarcinoma au fond de la
vesicule biliaire : C'est une masse de hyperdensite
intraluminal a bord tres net et irregulie
. Image radiologique TDM + contrast en coupe coronal |
|
Image d'une masse intraluminal , bord
irregulie a isodense avec la paroi ( adenocarcinoma
vesiculaire ) . Image hyperdense multiple des petits
calcules au fond de la vesicule biliaire est encore
en voyant |
|
| |
 |
|
 |
|
| |
Image radiologique carcinoma
de la vesicule biliaire , forme infiltrative avec
epaississement irregulier de la paroi avec
adenopathie hilaire et nodule metastasique foie
droit ( extension local et ganglionaire ) . Image
TDM en coupe axiale . |
|
Image radiologique IRM en coupe axiale
ponderee sur T2 : Image de masse
hyposignal intraluminale de la vesicule biliaire , a
bord irregulier . Voies biliaire intrahepatique est
dilate . Extension ganglionaire est en vue |
|
| |
 |
|
Meme cas en coupe coronale :
La vesicule biliaire est tres distendue avec lesion
en masse de tumeur au fondus . La voie biliaire
intra heaptique est tres dilatee ; Adenocarcinoma
vesiculaire |
|
| |
|
|
|
|
| |
 |
|
 |
|
| |
Image radiologique TDM d'une
adenocarcinoma vesiculaire en formation de masse
intraluminal a isodense avec la paroi .( coupe
axiale ) |
|
Image de PET -CT en coupe axiale de meme
cas . Demontration de lesion vesiculaire
hypermetabolique susgestion de maligne |
|
| |
|
|
|
|
Prognostic et
traitement : Traitemant curative est resection
de la vesicule biliaire au stade precoce . Le resulta de
survivre est :
- Survivre apres 1 ans est : 8O%
- Survivre apres 5 ans est : 1-5%
Page :
1
/
2
/
3
/
4
/
5
/
6
/7/
8/ 9
/
10
/11/
12
A suivre
<<
PREVIOUS
<<
>> NEXT >>
Gs Bui Binh Tho
,
|
|